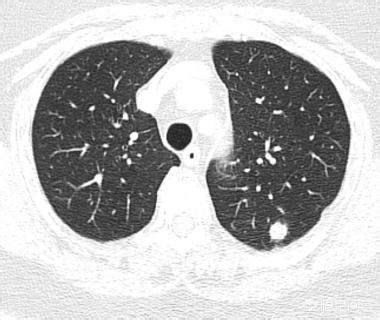

健康診断で見つかった "肺結節 "は本当に肺がんになるのか?
健康診断で見つかった "肺結節 "は本当に肺がんになるのか?
肺結節と肺がん、その関係は?
肺小結節とは直径1cm以下のものを指し、肺小結節の大きさと肺がんの可能性には正の相関があります。この回答では、小結節について説明します。
小肺結節と肺がんのもつれた関係を整理してみよう。
1.肺がんとして始まる小さな肺結節がある。
肺がんは腺がん、扁平上皮がん、大細胞がん、小細胞がん、カルチノイドがんなどに分類される。これらの癌が小さい場合は、大きい場合ほど典型的な癌ではない。
このような小さな肺結節を診断するためには、フィルム読影者の経験と、さまざまな尺度が必要である。
2.最初は癌ではない小さな肺結節がある。むしろ、異型腺腫性過形成などで、徐々に浸潤性腺がんに進展するもので、これは地上のガラス結節で最もよく見られる。
3.良性の小さな肺結節の中には、肺癌に進展しないものもある。
例えば肺内リンパ節は肺に小さな結節として現れ、ゆっくりと成長することさえあるが、これは良性で悪性化することはない。経過観察後に消失する地肌状の結節がありますが、これは炎症を示しています。その他の結節は結核、その他の炎症性疾患、良性腫瘍である。

4.癌でなくても手術しなければならない小さな肺結節がある。
例えば、硬化性肺細胞腫、部分奇形腫瘍などである。
5.癌ではないが、他のタイプの悪性腫瘍である小さな肺結節がある。
例えば、リンパ腫、転移、肉腫など。

肺結節が発見された場合、臨床的状況、CT所見などに基づいて分析する必要がある。結節が小さければ小さいほど、その特徴を把握するのが難しくなるため、経過観察が必要になることがある。
結節を見つけたらやみくもに積極的に手術することも、結節を見つけたらやみくもに楽観的に無視することもいけない。
健康診断で小さな肺結節が見つかる確率は高く、悪性より良性の方がはるかに多い。
検査の目的は肺がんに進展する可能性のある小さな結節を特定し、適切な時期に処理することで、中・末期の肺がんを予防する。。
病理学的には、小さな肺結節は3つのタイプに分けられ、それぞれ異なる管理原則がある:
1.良性結節
良性の肺結節は、一部は増殖や石灰化の病巣であり、一部はリンパ節であるが、古い結核、大気汚染、職業的吸入、長期喫煙、副流煙のために、多くの人の肺で検出される。
これは葉間胸膜の小さな結節で、このような葉間胸膜の孤立性結節はほとんどの場合良性であり、心配する必要はない。
2.悪性肺結節
例えば、混在するガラス結節では、良性よりも悪性の方が多い。
悪性腫瘍を裏付ける徴候には、以下のようなものがある:
1.胸膜の引きつれを伴う混合ガラス結節;
2.腫瘍細胞の付属器官の増殖を示唆する、断端の明瞭な地肌影;
3.内気管支気腹徴候は、やや硬く、拡張し、歪み、時に空胞徴候、血管貫通および肥厚、溝として感じられる。

これは外科的に確認された肺腺癌の症例である。
一方、固形肺結節では、悪性より良性の方がはるかに多い。悪性の肺結節には通常、バリ、小葉、気管支切断、棘突起、胸膜陥凹症状、血管集簇症状がみられる。
これは、山東省癌病院の黄教授による、非常に凝縮された実践的な要約である!
3.良性に見えるが肺がんに進展する可能性のある小さな結節
これらの小さな結節は、一見良性で滑らかで悪性腫瘍の徴候はないが、その後の経過観察中にサイズが大きくなり、徐々に悪性腫瘍の徴候が現れることがある。

このような4ミリほどの小さな固形結節は滑らかで、悪性腫瘍の明らかな兆候は見られなかった。しかし、2年4ヵ月後:
後に病理検査で小細胞肺がんであることが確認された。
では、肺がんの可能性のある小さな小結節をどうやって見分けるのか?
肺結節を見つけたらすぐに手術することはできない。それは人口の大多数を占める良性の結節を不当に殺してしまうことになるし、労多くして健康を損なうことになる。
どうすればいいのか?つのステップで:
1.悪性腫瘍の明らかな徴候のある小さな結節は切除する;
2.明らかな悪性腫瘍の徴候がない小さな結節については、経過観察とする。
ここまでくれば、私たちが肺結節を危険度に応じて等級分けしている理由がおわかりいただけるだろう:
ですから、健康診断で肺結節が見つかっても、まだ慌てる必要はありません。
地元の医師が経過観察を勧めるということは、少なくとも、肺がんであることはまだ確実ではなく、時間の経過とともにダイナミックに変化していく様子を見る必要があるということだ。
また、世界的なガイドラインによれば、このような経過観察は一般的に治療を遅らせることはない。
お読みいただきありがとうございます。お気軽にフォローしてください!
画像診断医のドクター・リトル・シャドーです。健康診断で出た小さな肺結節が、本当に肺がんになることがあります。ただ、健康診断で出てくる肺結節のほとんどは良性で、実際に肺がんになるのは10%以下です。
小さな肺結節が肺がんに成長した病歴
ちょうど2日前、私はある症例を読んだ。患者男性57歳、3年間の経過観察で、結節が0.5cmの大きさから肺がんになる過程を記録したばかりで、経過観察のたびに結節は大きくなっているが、患者は手術を選択しなかった。
矢印は結節を指しているが、2016年3月に発見されたときは約0.5cmと非常に小さかったが、今では定期検診でこのように非常に多くの結節が見つかっている。画像で良性か悪性かを判断する方法はなく、検討するという選択肢しかなく、検討と経過観察も最良の手段である。
7ヵ月後、2016年10月の2回目の経過観察では、この結節がより大きく、丸みを帯びていることが明らかになった。経過観察時の結節の拡大は悪性腫瘍の可能性を警告するものであったが、この患者はそれでも手術を選択しなかった。
さらに1年2カ月後、2017年12月に3回目の検査を受けた。この結節は以前よりずっと大きくなっており、悪性の徴候が小葉状に広がり、内部が固くなっているのがわかる。これらの徴候から、基本的に肺がんと診断されたが、それでも患者は手術を受けなかった。
結節は腫瘤(3cm以上)に変化しており、この肺がんは教科書的なもので、基本的に肺がんを支持する悪性腫瘍の兆候をすべて備えている。不規則な境界、小葉、バリ、胸膜の引きつれの徴候。
ありがたいことに、転移病変はまだ見られず、外科的切除も可能です。治療がまだ選択肢にないのであれば、1年後に再診に来れば、複数の転移性変化が期待できます。実際、2回目の再診では病変が大きくなっているのが見つかり、その時点で外科的切除を行うべきでしたが、基本的に再発も転移もありませんでした。病変が大きくなると、今度は血液中にがん細胞がある可能性があり、そうなると再発・転移のリスクが高くなります。
私は仕事柄、このようなケースに何度も何度も出会ってきた。
例えば、これは1年半後に見直したが、病変は拡大していた。
例えば、これは4年連続で観察したが、しこりは大きくなり続けていた。
早期の経過観察は病気を遅らせることはなく、経過観察で病変の拡大や悪性腫瘍の他の徴候が見つかった場合は、早期の外科的切除が必要である。
肺結節が見つかったらどうしたらいいかとよく聞かれる。CTで悪性腫瘍の徴候がなければ、例えば、このような小さな結節の場合、3ヵ月後か6ヵ月後に見直して、結節が大きくなっていれば早期に治療し、変化がなければ経過観察を続けるという選択ができます。経過観察が結節の転移につながることはなく、治療を遅らせることもない。また、結節の特徴を明らかにできない場合は、経過観察が最良の手段である。
それならもっと早く全部摘出すればいいのに、と言う友人もいた。すべての結節が悪性というわけではなく、悪性はごく一部であり、手術は悪性傾向のあるものだけに勧められるもので、過剰な外科治療をする必要はないからです。
肺結節は本当に癌であることもあるが、常に癌であるわけではない。
肺結節は、まず第一に3cm以下の肺の影を指し、3cmを超えるものは腫瘤と呼ばれる。肺結節は一般に密度によって固結と亜固結(すなわち、すりガラス結節)に分類される。肺結節は孤立性(すなわち1個)のものと多発性(すなわち複数個)のものがある。多層スパイラルCTの普及に伴い、無症状の肺結節が多く発見されるようになり、肺癌ではないかと心配される方も多いようですが、実際は心配する必要はなく、ほとんどが良性で、肺癌はごく少数です。
肺結節はどのようにして発見するのですか?
肺結節は通常、レントゲン(胸部X線)やCTを撮影して発見されますが、主にCTでは、多くの小さな結節は胸部X線では全く見えず、胸部CTで発見しなければなりません。それが、ヘッドラインでは多くの人が、毎年の健康診断では何の問題もないのに、なぜ突然肺がんになるのか?人間ドックではCTではなく胸部X線検査が行われたものと思われますので、検査項目の選択が重要です。例えば、肝臓や腎臓に実質的な病変(増殖)があるかどうかを見たければ超音波検査やCTを、消化管の病変を見たければ血液検査や尿検査などの検査項目だけでなく、胃カメラや大腸内視鏡検査をしなければなりませんが、多くの病変は検査項目で異常がないこともあります。ですから、肺の小さな初期病変や前癌病変、特に地中硝子小結節を発見するには、低線量スパイラルCTをお勧めします。
肺結節が見つかった場合の対処法?
肺結節を見つけるための次のステップは、良性か悪性かを判断することである。良性の結節は、肺のリンパ節、形の悪い腫瘍、硬化性肺細胞腫など、間違いなく何でもないものである。残りの結節は良性または悪性の可能性があるもので、このような結節に対する治療の一般原則は経過観察を勧めることであり、結節の特異性(形態、大きさ、密度など)に応じて、見直しの時期は3ヵ月から1年である。結節の中には、炎症性結節のように経過観察中に吸収されて消失するものもあれば、肉芽腫のように変化しないものもあり、これは良い情報である。経過観察中に、結節の肥大、すりガラス結節の中の実成分や固形成分の増加、結節の緻密化、末梢血管が伸びているのが見えるなど、悪性の徴候があれば、積極的に対処すべきです。実際、人を見るように、正義の顔は、一般的に良い人、凶暴で悪質な悪人であり、いくつかの一時的な人の行動の観察を通じてのみ見ることができない、ルールは一般的に恐れていない場合は、悪い行動があることを発見した場合は、タイムリーに対処する必要があります。図1、左肺上部のすりガラス状の結節(オレンジ色の矢印)を発見し、2年以上経過観察したが変化なし。図2、右肺上部に2個の小さなすりガラス結節(オレンジ色の矢印)、2年後に消失した。図3、右肺上部のすりガラス状の小結節、3回目の経過観察で大きくなっているので、前向きに対処することを勧め、外科的病理検査でin situ癌、つまり前癌病変を発見すれば、肺癌の芽を摘むことができる。



低線量CT肺がん検診を毎年受けることを推奨されるのはどのような人ですか?
肺がんのリスクが高い人には年1回の検診が推奨される。すなわち年齢が40歳以上で、以下のいずれかに該当する者:喫煙≧20箱/年(または400本/年)、または喫煙経験はあるが禁煙して15年未満。アスベスト、ウランなど)。慢性閉塞性肺疾患、びまん性肺線維症、結核の既往を合併している。悪性腫瘍または肺がんの家族歴。
ノックアウト:肺結節の発見は深刻に受け止めるべきですが、心配しすぎる必要はありません。 肺結節は癌の可能性もありますが、ほとんどは良性で、初期の肺癌や前癌病変は早期に発見して治療すれば予後は非常に良好です。
私はそうだ。映画ドクター C・ハオもし、その答えに興味があれば、さらに関連記事を見ることができる。
結節といえば、まず肺の小結節の症例を見てみよう。 この患者は風邪で咳があり、胸部CT検査で右肺にすりガラス状の結節が見つかり、層厚1mmの右肺上葉のCT断面像で、大きさ6mm、その固形部分(矢印)は4mm以下の部分固形結節を認めた。境界は明瞭で、病歴から炎症性であると考えられ、炎症の再検討を勧められた。
3ヵ月後のフォローアップCT画像では、病変は完全に消失しており、良性の病因と一致した。

この症例は、肺の小さな結節がすべて悪性であるわけではなく、すべてが肺癌になるわけではないことを示している。
では、肺がんになる可能性のある結節とはどのようなものだろうか?
肺の小さな悪性結節はしばしば典型的な悪性腫瘍の徴候を示し、結節内部の密度はしばしば不均一で、初期の結節ではすりガラス状になったり、すりガラス状の密度が混在するものもあり、結節の一部に小さな空洞が見られることもある。悪性結節は栄養補給のために大量の血液を必要とするため、辺縁部にはしばしば短いバリが浸潤しているのが見られ、血管集塊と呼ばれる小さな血管の集合体が小結節の小血管に近接して見られることもあるため、辺縁部はさらに典型的である。
肺に上記のような徴候のある疑わしい結節を見つけたら、特に混合バリ結節に高い注意を払うべきで、これは時間内に治療するか、あるいは綿密に経過観察すべきです。また、よく地肌結節と呼ばれるものがありますが、地肌結節は密度と縁、また経過観察時間とプログラムの直径の大きさに基づいて、炎症性結節と考えられる場合は、抗炎症後に結節の変化の吸収と縮小があるかどうかを観察して比較検討する必要があります。肺に小さな結節が見つかった場合は、神経質にならず、結節の特異的な症状に応じて、他の臨床検査を行い、検査や経過観察に進む必要があるかどうかを判断する。
誰もがそれが悪くないと思うなら、私はサポートを賞賛することを願って、下にメッセージを残すために歓迎質問を持っている、あなたはすべての励ましが前進するために私の力です!
実はこの質問は科学的ではありません。どの肺結節が肺がんで、どの肺結節が肺がんでないかということである。なぜなら、肺結節は画像診断の概念であり、肺癌は病理の診断だからである。
近年、人々の健康意識の高まりや検診方法の進歩に伴い、肺結節が発見される機会が増えています。45歳以上の健康な人が胸部エコー検査を受けると、約1/3以上の人の肺に結節が見つかるという報告もあります。
肺結節の原因はいろいろあるが、肺癌を除けば、小さな肺結節のほとんどは良性である。これらの良性肺結節では、主に感染症、結核、真菌などの肺の炎症が原因です。良性の炎症性結節とは別に、悪性腫瘍や血管腫など、肺結節として現れる良性腫瘍もあります。したがって、肺結節を見つけたら、それが何によるものかを判断する必要があります。
肺結節の中には、肺がんや肺腫瘍の初期症状、つまり腫瘍が成長したばかりで結節が比較的小さいものもあるため、良性か悪性かの判断が難しく、医師は鑑別診断のために患者に検査を受けさせ、前後比較をして、結節の成長に変化があるかどうかを観察する。
そのため、結節が肺がんになったとは言えず、結節自体が前がん病変や肺がんの初期状態である可能性があり、一定期間観察して肺がんかどうかを確認する必要があるだけです。
健康診断で発見される肺結節のうち、早期肺癌はごく少数であり、ほとんどは良性病変である。良性の肺結節のほとんどは、肺のリンパ節、炎症斑、増殖巣であり、通常は肺癌の方向には進展しない。しかしこれらの非定型腺腫様過形成病変の中には、肺がんに進行する可能性のあるものもあるが、一生変化がない場合もある。
一般的に、病変が小さく、濃度が薄すぎる微小な地中結節については、経過観察と観察を続けることをお勧めします。しかし、体内にリスクを残したくないという患者さんの中には、摘出手術を強く希望される方もいらっしゃいます。。
通常、異型腺腫性過形成の病変は5mm以内で、8mmを超えることは比較的まれである。下は8mm大の異型腺腫様過形成のCTと病理像である。
手術の機会に達していないと思われる、あるいは非定型腺腫様過形成の段階にある可能性のある地肌結節の場合。経過観察中に、すぐに手術が必要な状態とは??フィルム読者は、病変の前後を注意深く比較し、もし病変が見つかったら病変が以前の病変よりわずかに大きいか、あるいはわずかに密度が高いか、あるいは血管が病変の中に伸びているのが見つかる。例えば、下の写真は手術の時期だ。
加えて非常に小さく、病変の特徴から良性と考えられる固結節もあるが、それでも医師の要求に従って定期的な経過観察が必要である。。
以上、ご参考になれば幸いです。
をフォローする歓迎 @MedicalScienceDr Xu
不快な症状もなく、健康診断で小さな肺結節が見つかり、37歳の張さんはお茶を飲み始め、心配になり、肺がんから遠くはないと思ったが、子供は幼稚園に行ったばかりで、両親は高齢で世話が必要で、どう向き合えばいいのかわからなかった。しかし、王薬剤師は、これはそうではないということです。

小さな肺結節はどこから来るのか?
鼻や口から肺に入る気体には、ほこりやその他の異物が含まれており、通常、気道繊毛に吸着されて喉に運ばれ、そこで異物感を刺激し、咳をすることで排除される。しかし、繊毛はこれらの異物を100%除去できるわけではないため、一部の小さな粒子は肺胞に沈着し、そこで免疫細胞やリンパ球がそれらを見つけ、「処理」してカプセル化し、肺に石灰化した斑点や結節を形成する。
言い換えれば、小さな肺結節は身体の正常な生理的反応として形成される。
小さな肺結節=肺がん?
現実には、小さな肺結節が見つかってから数年後に肺がんと診断される人が実際にいますが、小さな肺結節は確実に肺がんに発展するのでしょうか?答えは明らかにノーです。
ほとんどの肺結節は、通常、細菌やウイルスなどの異物を吸い込むことによって、免疫細胞が炎症性の「包み込む」反応を起こして動員され、排除される。アレルギーによる肺結節の場合、最終的に良性の腫瘍が形成されることもある。免疫細胞によって包まれた異物が徐々に成長し、遺伝子の変化を引き起こすためである。
とはいえ、発見された小さな肺結節が肺がんに発展する可能性は、100%ではないがある!

小さな肺結節はどのように管理すべきか?
では、小さな肺結節が発見された場合、最も科学的な対処法は何だろうか?
まず、専門の医師が診断します。結節の大きさや形、患者の全身状態から、医師は手術で摘出すべきか、経過観察にとどめるべきかを判断する。一般的に、1インチ以上の大きさの充実性結節、毛の生えたガラスのような結節、その中間の混合結節は、特に注意深く観察する必要がある結節です。また、肺がんの家族歴があったり、過去に腫瘍の既往があったり、長期喫煙者であったりする場合も注意が必要です。
第二に、定期的なスクリーニング
肺結節の90%以上は異常が現れませんが、吐血、高熱、痛みなどの症状が出た場合は、すでに肺がんに進行しているか、進行していることを意味します。したがって、たとえ症状がなくても、小さな肺結節のある人は、早期発見と治療介入のために定期的な検診を受けるべきです。

複雑で難しい病気の知識を平易な言葉で説明し、皆様の身体管理のお役に立てるよう日々精進している王薬剤師です。皆様からのお褒めの言葉が私の最大のモチベーションです!また、もしあなたのご家族も関連する悩みをお持ちでしたら、ぜひこの記事を伝えてあげてください!
その質問には喜んでお答えしますよ!
健康診断で発見された "肺結節 "は本当に肺がんになるのか?
この問題は、多くの人々を悩ますと言うことができる、彼らの肺の発見以来、多くのものがある結節、お茶やご飯を成長し、それをカットするために手術に行くかどうかを一日中考えて、すべての結果は、また、炎症性病変または陳腐な結節であることが判明し、ずっと前に、ユニットの福祉があまりよくない直前に、彼らに毎年の健康診断の利点を提供しませんでした!
この質問によって、肺の結節を体内で発見した人に、そもそも肺の結節を外科的に切除することは確かに勧められないということをお伝えできればと思います。特に、肺に突然の結節が見つかったという最初のCT所見は、比較の根拠がなく、臨床的には、最初に見つかった肺の結節が悪性である可能性が高いかどうかという前後比較に重点が置かれている初めて恋人に会ったとき、彼女が太ったのか痩せたのかわからないのと同じで、このときにやみくもに結論を急ぐのは根拠がなく、誤解を招きやすい!したがって、最初の健康診断で肺小結節が見つかった場合、パニックに陥らず、定期的な検査に注意し、手術を急がないことを強調します。
なぜ肺に結節があっても肺癌とは限らない。 肺癌かどうかを調べるには、胸部CT検査を見るだけでなく、結節の変化、腫瘍マーカー、肺癌に関連する抗体、遺伝子配列の決定など、一連の結果を定期的に観察し、最終的により適切な診断を下す必要がある。肺の結節が肺がんに進展する可能性はあるとしか言いようがないが、可能性は大きくない。 肺の結節に悪性変化があると疑われた患者の多くが切除手術を受けた結果、半数近くが早期の肺がんではないことがわかった!
肺小結節の80%は良性であると言ってよい。もちろん、短期間の急激な腫大やバリのあるしこりの場合は悪性を強く疑う必要がある。半透明のすりガラス状結節の場合は、8MM以下であれば観察が可能であり、短期間の腫大は治療が必要である。前癌病変の可能性があるからである。
ちなみに、江蘇省癌病院では毎週火曜日の午後に肺結節の専門クリニックを開いており、胸部外科、放射線治療、画像診断、化学療法の専門家が集まって、結節を持つ患者に最良の選択肢を提供できるはずである。
ようこそ、私のヘッドライン-江蘇省癌病院李鳳に従ってください。個人的にチャットすることができます。
この質問と回答はサイト利用者のものであり、サイトの立場を代表するものではありません、侵害など、削除するには管理者に連絡してください。